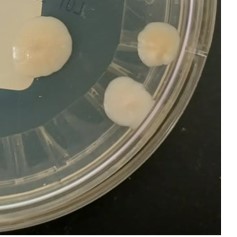

Case History
An elderly male with a complex past medical history presented to the Emergency Department with the primary complaint of chest tightness for 2 days. He denied symptoms of diaphoresis, nausea, shortness of breath, palpitations, light-headedness, productive cough, dyspnea, chest pain, fevers, chills, or hemoptysis. He had no known sick contacts or recent travel. A computer tomography (CT) scan of the thorax showed a right hilar mass (Image 1). He underwent a bronchoscopy and right hilar transbronchial needle aspiration (TBNA) and bronchoalveolar lavage (BAL) were collected. The pathology report indicated abnormal lymphocytic proliferation, concerning for a mature small B-cell lymphoproliferative disorder.

The BAL was submitted for acid-fast bacteria (AFB) culture, Gram stain, aerobic bacterial culture, and fungal culture. The AFB culture, Gram stain, and bacterial culture were all negative. However, 3 tan-yellow creamy colonies of a yeast grew on the sabouraud dextrose agar (SAB) plate in fungal culture after 7 days (Image 2). An India ink stain was performed (Image 3). MALDI-TOF confirmed the identification as Cryptococcus neoformans.

Discussion
Cryptococcus neoformans is an encapsulated pathogenic yeast, which is typically associated with bird droppings and contaminated soil.1,2 In immunocompromised patients, it can lead to severe opportunistic infections such as meningitis or disseminated disease. C. neoformans can cause life-threatening fungal infections in these patients, especially those with T-cell mediated immunodeficiency.3,4 The three main virulence factors include the complex capsule, melanin production, and ability to grow at human body temperature.5,6 Signs of pulmonary infection include cough, production of mucoid sputum, pleuritic chest pain, low-grade fever, dyspnea, weight loss, and malaise.
Fungal culture is one of the primary methods of Cryptococcus identification. Upon microscopic examination, Cryptococcus appears as a single bud and a narrow neck between parent and daughter cell and measures 4 – 10 uM.7 It has a fragile cell wall and a polysaccharide capsule that can vary from a wide halo to a nearly undetectable zone around the cells. Colonies can exhibit a wide range of color (i.e. cream, tan, pink, or yellow) and typically grow within one week of inoculation.8,9 India ink smear is a rapid method that allows direct visualization cryptococcal capsule, but is infrequently used now. Certain non-specific histological stains (including Periodic Acid-Schiff and May-Grünwald-Giemsa) can be used to detect fungi directly in fixed specimens. Fontana-Masson is a silver stain used for detecting melanin and has a high sensitivity for cryptococcosis.10 Other useful stains include hematoxylin-eosin, which reveals the clear halo, and mucicarmine and alcian blue, which target the polysaccharide capsule.11 Cryptococcal serology and cryptococcal antigen testing can be used for blood or CSF infections. Radiographic findings (especially in asymptomatic and immunocompetent patients) include patchy pneumonitis, granulomas (typically 2-7 cm), and miliary disease similar to tuberculosis.8 Treatment will vary depending on location of infection and host immune status. In some cases, pulmonary Cryptococcus may not be treated. Some clinical considerations include:
- CSF chemistry parameters are normal
- CSF culture, cryptococcal antigen, India ink preparation, and serology results are negative
- Urine culture results are negative
- Pulmonary lesion is small and stable/shrinking
- No predisposing conditions for disseminated disease6
If treatment is required, fluconazole, itraconazole, or amphotericin B with or without flucytosine can be used depending on severity of infection.12
Cryptococcus gattii is another species of Cryptococcus. It differs from C. neoformans in that it typically infects both immunocompromised and immunocompetent patients. Canavine glycine bromothymol blue (CBG) agar can be used to differentiate C. gattii from C. neoformans: C. gattii is able to grow in the presence of canavine, turning the agar blue, while C. neoformans does not, leaving the media color unchanged.13,14
References
- Hagen, F., Khayhan, K., Theelen, B., Kolecka, A., Polacheck, I., Sionov, E., Falk, R., Parnmen, S., Lumbsch, H. T., and Boekhout, T. Recognition of seven species in the Cryptococcus gattii/Cryptococcus neoformans species complex. Fungal Genet Biol. 2015; 78: 16-48.
- Lortholary, O., Nunez, H., Brauner, M. W., and Dromer, F. Pulmonary cryptococcosis. Semin Respir Crit Care Med. 2004; 25: 145–57.
- Lanternier, F., Cypowyj, S., Picard, C., Bustamante, J., Lortholary, O., Casanova, J. L., and Puel, A. Primary immunodeficiencies underlying fungal infections. Curr Opin Pediatr. 2013; 25: 736–47.
- National Organization for Rare Disorders (NORD). Cryptococcosis. Available from: https://rarediseases.org/rare-diseases/cryptococcosis/ Last updated 2007; cited 2021 October 8.
- Idnurm, A., Bahn, Y.-S., Nielsen, K., Lin, X., Fraser, J. A., and Heitman, J. Deciphering the model pathogenic fungus Cryptococcus neoformans. Nat Rev Microbiol. 2005; 3(1): 753-64.
- Vandeputte, P., Ferrari, S., and Coste, A. T. Antifungal Resistance and New Strategies to Control Fungal Infections. Int J Microbiol. 2012: 713687.
- Guarner, J. and Brandt, M. E. Histopathologic Diagnosis of Fungal Infections in the 21st Century. Clin Microbiol Rev. 2011; 24(4): 247-80.
- Borman, A. M. and Johnson, E. M. (2020). Candida, Cryptococcus, and Other Yeasts of Medical Importance. Manual of Clinical Microbiology, 12th Edition. Washington, DC: ASM Press. 2056-86.
- Coelho, C., Bocca, A. L., and Casadevall, A. The tools for virulence of Cryptococcus neoformans. Adv Appl Microbiol. 2014; 87: 1-41.
- Bishop, J. A., Nelson, A. M., Merz, W. G., Askin, F. B., and Riedel, S. Evaluation of the detection of melanin by the Fontana-Masson silver stain in tissue with a wide range of organisms including Cryptococcus. Hum Pathol. 2012; 43(6): 898-903.
- Guery, R., Lanternier, F., Pilmis, B., and Lortholary, O. Cryptococcus neoformans (Cryptococcosis). Antimicrobe. Available at: http://www.antimicrobe.org/new/f04.asp. Last updated: 2014; cited 2021 October 8.
- Perfect, J. R., Dismukes, W. E., Dromer, F., Goldman, D. L., Graybill, J. R., Hamill, R. J., Harrison, T. S., Larsen, R. A., Lortholary, O., Nguyen, M.-H., Pappas, P. G., Powderly, W. G., Singh, N., Sobel, J. D., and Sorrell, T. C. Clinical Practice Guidelines for the Management of Cryptococcal Disease: 2010 Update by the Infectious Diseases Society of America. Clinical Infectious Diseases. 2010; 50(3): 291-322.
- Larone, D. (2011). Medically Important Fungi. Washington, DC: ASM Press.
- Klein, K. R., Hall, L., Demi, S., Rysavy, J. M., Wohlfiel, S. L., and Wengenack, N. L. Identification of Cryptococcus gattii by use of L-canavanine glycine bromothymol blue medium and DNA sequencing. J Clin Microbiol. 2009; 47: 3669-72.

-Marika L. Forsythe, MD is a PGY1 Pathology Resident at University of Chicago (NorthShore). Her academic interests include molecular diagnostics and its growing importance in the field of pathology.

-Paige M.K. Larkin, PhD, D(ABMM), M(ASCP)CM is the Director of Molecular Microbiology and Associate Director of Clinical Microbiology at NorthShore University HealthSystem in Evanston, IL. Her interests include mycology, mycobacteriology, point-of-care testing, and molecular diagnostics, especially next generation sequencing.
Very informative..Thanks
you’re great sir, thank you very much for the amazing content